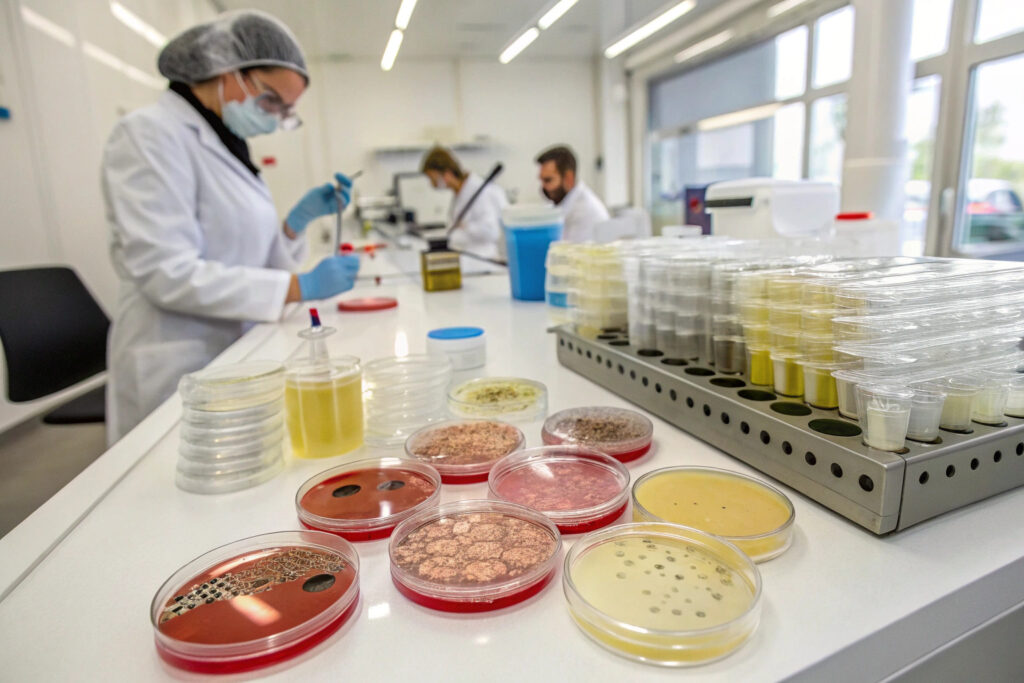

Antimicrobial claims on fabric face coverings have proliferated in the marketplace, creating both consumer confusion and regulatory scrutiny. With everything from "99.9% antibacterial" to "odor-fighting" appearing on mask labels, brands face the challenge of substantiating these claims with legitimate scientific evidence that withstands regulatory examination and builds genuine consumer trust.
Validating antimicrobial efficacy claims in treated cloth face coverings requires standardized laboratory testing following established protocols like ISO 20743 and AATCC 100, verification through third-party certification, and clear communication about what specific microorganisms the treatment targets and under what conditions. Proper validation involves both quantitative reduction testing and real-world simulation to ensure claims are both scientifically valid and practically meaningful.
The validation process must address not just whether the antimicrobial treatment works in laboratory conditions, but whether it provides meaningful benefits in actual use scenarios and maintains effectiveness through the product's expected lifespan. Let's examine the specific validation approaches that ensure claims are defensible and valuable to consumers.
What Standardized Testing Methods Provide Valid Results?
Laboratory testing following internationally recognized standards provides the foundation for defensible antimicrobial claims.

How does quantitative reduction testing work?
The ISO 20743 standard provides three quantitative evaluation methods (absorption, transfer, and printing) that measure the reduction percentage of specific microorganisms after contact with treated fabric. This testing typically uses representative bacteria like Staphylococcus aureus (Gram-positive) and Klebsiella pneumoniae (Gram-negative) to demonstrate broad-spectrum efficacy. A valid claim requires demonstrating significant reduction (typically 2-3 log reduction, equating to 99-99.9%) compared to untreated control fabrics under controlled conditions. Our laboratory testing follows this standard with additional validation at independent third-party facilities.
What about the AATCC 100 method?
AATCC Test Method 100 measures the reduction of microorganisms quantitatively after inoculation directly onto textile specimens. This method provides percentage reduction calculations and is widely accepted in North American markets. The testing involves inoculating fabric samples with a known concentration of test organisms, incubating for a specified contact time (typically 24 hours), then enumerating surviving organisms to calculate reduction percentage. For credible claims, we require minimum 99% (2-log) reduction against both Gram-positive and Gram-negative bacteria.
How Do You Verify Long-Term Efficacy and Durability?
Antimicrobial treatments must maintain effectiveness through the product's expected lifespan, not just when new.

What washing durability standards apply?
ISO 20743 includes washing procedures that simulate real-world use, typically requiring treatments to maintain efficacy through a specified number of wash cycles (often 10-50 cycles depending on claim requirements). The most credible claims specify the number of washes the treatment withstands while maintaining effectiveness. Our validation process includes testing after 5, 10, 25, and 50 industrial washing cycles following ISO 6330 standards, providing data to support specific durability claims.
How is real-world performance simulated?
Beyond standard washing tests, simulated use testing evaluates how antimicrobial performance holds up under conditions masks actually experience—including exposure to saliva, sweat, and repeated flexing. This involves creating artificial perspiration and saliva solutions, subjecting treated fabrics to mechanical action simulating wear, and then retesting antimicrobial efficacy. This comprehensive approach has identified treatments that perform well in laboratory conditions but degrade quickly in actual use.
What Certification and Verification Systems Build Credibility?
Third-party verification provides objective validation that goes beyond manufacturer-conducted testing.

What role do accredited laboratories play?
Testing conducted by ISO 17025 accredited laboratories provides the highest level of credibility, as these facilities undergo rigorous assessment of their technical competence and quality systems. Accreditation specific to antimicrobial testing standards ensures the laboratory has demonstrated proficiency in these specific methodologies. Our validation process always includes testing at accredited facilities, with documentation of the accreditation scope covering the specific test methods used.
How do specific antimicrobial certifications help?
Certifications like the SIAA (Society of International Sustaining Growth for Antimicrobial Articles) mark in Japan or specific EPA registrations in the United States provide independent verification of antimicrobial claims. These certifications require submission of comprehensive testing data and manufacturing documentation for review by regulatory bodies. While not all markets require such certifications, they provide strong evidence of claim validity and demonstrate commitment to transparency.
What Claims Language Withstands Regulatory Scrutiny?
How antimicrobial benefits are communicated significantly impacts regulatory compliance and consumer understanding.

What's the difference between "antibacterial" and "antimicrobial"?
"Antibacterial" claims specifically refer to activity against bacteria, while "antimicrobial" is a broader term that can include efficacy against fungi, viruses, and other microorganisms. The specific terminology used should match the testing conducted—antibacterial claims require testing against bacteria only, while antimicrobial claims should demonstrate efficacy against multiple microorganism types. We recommend specifying which microorganisms the treatment targets rather than using broad, undefined "antimicrobial" claims.
How should reduction percentages be communicated?
Claims like "99.9% reduction" must be qualified with specifics about which organisms, under what conditions, and over what time period. The most defensible claims follow the structure: "[Product] demonstrated a [percentage] reduction of [specific microorganisms] within [time period] when tested according to [standard method]." This precision prevents misinterpretation while providing the scientific context needed to evaluate the claim's significance. Our labeling guidelines include this structured approach to claim communication.
What About Viral Efficacy Claims?
Antiviral claims represent a different level of validation with distinct testing requirements and regulatory considerations.

How are antiviral claims validated?
ISO 18184 provides the standard methodology for measuring antiviral activity of textile products. This testing uses specific enveloped viruses (like influenza) and sometimes non-enveloped viruses to demonstrate broad-spectrum activity. Antiviral testing requires specialized biosafety facilities and expertise beyond bacterial testing. Valid claims require demonstrating significant reduction (typically ≥3 log reduction for strong claims) within specified contact times.
What regulatory considerations apply to antiviral claims?
In the United States, antiviral claims typically trigger EPA regulation under the Federal Insecticide, Fungicide, and Rodenticide Act (FIFRA), requiring registration of the treatment as a pesticide. This involves extensive testing and review processes far beyond self-declared claims. Many international markets have similar regulatory frameworks for antiviral claims. We guide clients through this complex regulatory landscape to ensure compliance while making meaningful, accurate claims.
How Do You Address Safety and Environmental Concerns?
Antimicrobial treatments must be safe for users and environmentally responsible throughout their lifecycle.

What safety testing is required?
Biocompatibility testing following ISO 10993 standards evaluates potential for skin irritation and sensitization, particularly important for products with prolonged skin contact like masks. Additionally, testing for leaching or migration of antimicrobial agents ensures they don't transfer to skin in concerning quantities. Our material safety dossier includes both efficacy and safety data, providing comprehensive product understanding.
How is environmental impact assessed?
Evaluating environmental fate and toxicity of antimicrobial treatments is increasingly important for environmentally conscious brands and consumers. This includes assessing biodegradability of the treatment, potential aquatic toxicity, and impacts on wastewater treatment systems. We prioritize antimicrobial technologies with favorable environmental profiles and provide transparent documentation about environmental characteristics.
Conclusion
Validating antimicrobial efficacy claims in treated cloth face coverings requires a multi-faceted approach combining standardized laboratory testing, third-party verification, careful claims construction, and comprehensive safety assessment. The most defensible validation programs demonstrate not just initial efficacy but durability through the product's lifespan, specificity about which microorganisms are affected, and transparency about testing methodologies and limitations.
Beyond mere regulatory compliance, robust validation builds consumer trust and brand reputation by ensuring claims are both scientifically valid and practically meaningful. In a market crowded with antimicrobial assertions, thorough validation becomes a competitive advantage that separates credible products from marketing hype.
Ready to develop and validate legitimate antimicrobial claims for your fabric face coverings? Contact our Business Director, Elaine, at elaine@fumaoclothing.com to discuss our comprehensive testing protocols and regulatory guidance. We'll help you create defensible, meaningful antimicrobial claims that build consumer trust while maintaining full regulatory compliance.